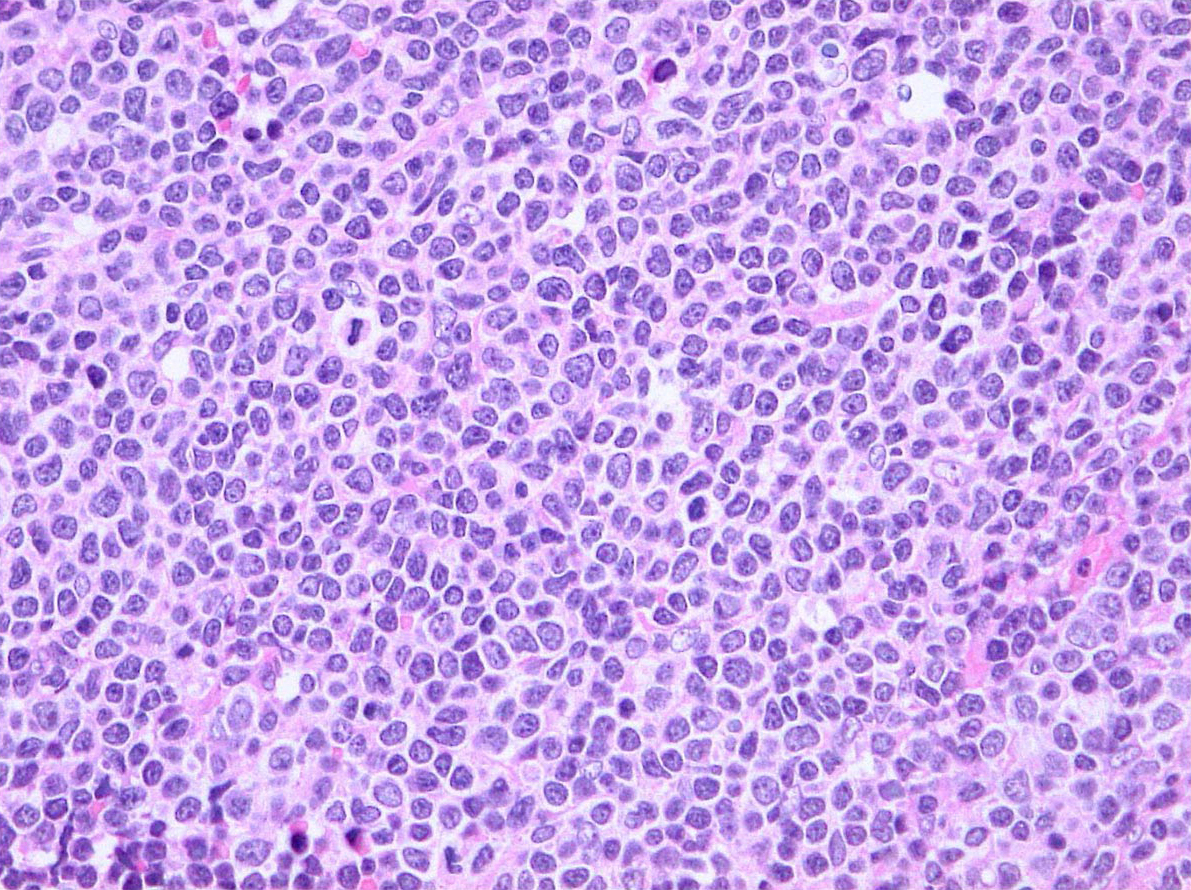
mantle-cell-lymphoma.jpg

On November 14, 2019, the Food and Drug Administration granted accelerated approval to zanubrutinib (BRUKINSA, BeiGene, Ltd.) for adult patients with mantle cell lymphoma (MCL) who have received at least one prior therapy.
Efficacy was evaluated in BGB-3111-206 (NCT03206970), a phase 2 open-label, multicenter, single-arm trial of 86 patients with MCL who received at least one prior therapy. Zanubrutinib was given orally at 160 mg twice daily until disease progression or unacceptable toxicity. Efficacy was also assessed in BGB-3111-AU-003 (NCT 02343120), a phase 1/2, open-label, dose-escalation, global, multicenter, single-arm trial of B‑cell malignancies, including 32 previously treated MCL patients treated with zanubrutinib administered orally at 160 mg twice daily or 320 mg once daily.
The primary efficacy outcome measure in both trials was overall response rate (ORR), as assessed by an independent review committee. In trial BGB-3111-206, FDG-PET scans were required and the ORR was 84% (95% CI: 74, 91), with a complete response rate of 59% (95% CI 48, 70) and a median response duration of 19.5 months (95% CI: 16.6, not estimable). In trial BGB-3111-AU-003, FDG-PET scans were not required and the ORR was 84% (95% CI: 67, 95), with a complete response rate of 22% (95% CI: 9, 40) and a median response duration of 18.5 months (95% CI: 12.6, not estimable).
The most common adverse reactions (≥20%) included decreased neutrophil count, decreased platelet count, upper respiratory tract infection, decreased white blood cell count, decreased hemoglobin, rash, bruising, diarrhea, and cough. The most common serious adverse reactions were pneumonia in 11% and hemorrhage in 5% of patients.
The recommended zanubrutinib dose is 160 mg orally twice daily or 320 mg orally once daily.